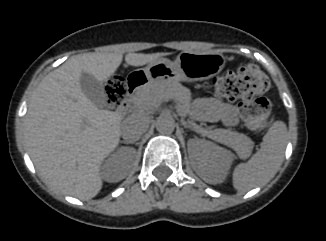

КТ желчного пузыря в СПБ
КТ желчного пузыря в СПБ
- Введение контраста Нет
- Длительность выполнения 10 минут
- Ограничения по весу 120 кг
- Ограничения по возрасту От 15 лет
- Срок получения результата В течение дня
Мультиспиральная компьютерная томография желчного пузыря применяется для оценки состояния стенок желчного пузыря, изучения содержимого его полости, выявления воспалительных изменений, конкрементов и опухолевых новообразований.
Методика основана на применении рентгеновского излучения, с помощью которого томограф производит послойные срезы исследуемой области для получения изображений в мельчайших подробностях.
В клинике «Доступная медицина» исследование проводится на новейшем 128-срезовом томографе TOSHIBA AQUILION CXL, который позволяет проводить исследование за короткий промежуток времени при сниженной лучевой нагрузке. Посредством инновационных компьютерных программ томограф преобразует полученные данные в 3D-изображения желчного пузыря и желчевыводящих протоков. Это помогает диагностировать заболевания гепатобилиарной системы особенно при нетипичной клинической картине, когда при помощи других методов обследования (УЗИ, МРТ) не удается выявить причину нарушения оттока желчи из желчного пузыря.
МСКТ желчного пузыря в большинстве случаев проводится с применением контрастирования. Пациенту внутривенно вводится рентгеноконтрастное вещество на основе йода. Препарат с током крови попадает в исследуемую область и усиливает контрастность патологических участков, что делает их видимыми на фоне здоровых тканей. При подозрениях на онкологический процесс метод компьютерной томографии с контрастированием помогает обнаружить патологию на раннем этапе развития и провести своевременное лечение.
- Показания к проведению КТ желчного пузыря
- Что покажет КТ желчного пузыря
- Подготовка к компьютерной томографии желчного пузыря
- Противопоказания к проведению КТ желчного пузыря
Показания к проведению КТ желчного пузыря
- отклонения в работе пищеварительного тракта;
- аномалии развития органа;
- желчная гипертензия;
- камни (рентгеноконтрастные) в желчном пузыре;
- острый и хронический холецистит
- желтуха;
- подозрения на опухолевые образования;
- дискинезия желчевыводящих путей
- острый и хронический холангит
- анализ результатов проведенной терапии.
Что покажет КТ желчного пузыря
- камни желчного пузыря и его протоков;
- холангит и холецистит;
- абсцессы;
- нарушения кровоснабжения, травмы, кровоизлияния;
- воспалительные процессы в желчном пузыре и поджелудочной железе.
Подготовка к компьютерной томографии желчного пузыря
Достижению максимального результата от компьютерной томографии желчного пузыря поможет:
- уточнение рисков развития аллергических реакций на содержащие йод контрастные вещества;
- уточнение рисков нефротоксической реакции на контрастные вещества. Все пациенты должны сдать анализ крови на креатинин не позднее, чем за 14 суток до проведения компьютерного сканирования. Его результат поможет лечащему врачу сделать вывод о возможности проведения такого обследования.
- последний прием пищи за 2-3 часа до обследования. Запрет на прием пищи в эти часы не распространяется на больных сахарным диабетом.
Просим пациентов перед проведением КТ желчного пузыря предоставить максимально большое количество медицинской документации, включая:
- направление на обследование;
- результаты предыдущих КТ, МРТ, УЗИ;
- заключения специалистов;
- данные лабораторных исследований желчи.
Должны предупредить пациентов о возможном появлении на КТ -снимках артефактов (дефекты визуализации, затрудняющие оценку состояния изучаемого органа). Такие явления развиваются, если:
- накануне компьютерной томографии пациент проходил рентгенологическое исследование органов брюшной полости с бариевой взвесью. Это вещество оставляет на послойных снимках выраженные тени.
- при наличии на теле ив организме металлических предметов. Поэтому перед обследованием органов брюшной полости мы просим снять с тела все металлические предметы (украшения, ремни, пирсинг), а при наличии кардиостимуляторов,протезов, штифтов, инсулиновых помп, осколков сообщать об их наличии специалистам центров.
Пациенты с сахарным диабетом, нуждающиеся в проведении такого исследования должны отказаться от приема препаратов Метформин и (или) Глюкофаж на срок до 48 часов до и после компьютерного сканирования с контрастом.
Противопоказания к проведению КТ желчного пузыря
Абсолютными противопоказаниями к проведению такого информативного исследования являются:
- беременность, из-за риска навредить здоровью плода лучевой нагрузкой;
- аллергические реакции на контрастные вещества и почечная недостаточность. При заболеваниях почек в анамнезе пациента, для уточнения возможности проведения КТ обязательно выполняются анализы креатинина.
Также противопоказаниями являются:
- психические заболевания с нарушениями двигательной моторики;
- клаустрофобия;
- период грудного вскармливания. При выполнении КТ желчного пузыря с контрастированием необходимо предусмотреть временный (24-48 часов) отказ от вскармливания младенца материнским молоком;
- вес пациента свыше 120 кг (такой запрет определен техническими возможностями используемых нами томографов).
Существует ряд состояний и патологий, при которых проведение компьютерного сканирования желчного пузыря будет затруднено:
- декомпенсированный сахарный диабет;
- тяжелая форма бронхиальной астмы;
- миеломная болезнь;
- лечение радиоактивным йодом;
- патологические состояния щитовидной железы;
- выраженный болевой синдром, не позволяющий пациенту удерживать тело в момент процедуры неподвижно.
При наличии противопоказаний альтернативой компьютерной томографии служит МРТ желчного пузыря, которая в нашей клинике выполняется на современном высокопольном магнитно-резонансном томографе экспертного уровня по сниженным ценам.
Как записаться на эту процедуру, вы можете узнать у дежурного администратора по телефону справочной службы центров: +7(812) 380-83-84с 9:00 до 22:00.
Запишитесь на КТ желчного пузыря по удобному адресу
ЗаписатьсяСтанция метро
Площадь Восстания Проспект Просвещения Нарвская Рыбацкое Девяткино Гражданский проспект Академическая Политехническая Площадь Мужества Лесная Выборгская Площадь Ленина Чернышевская Владимирская Пушкинская Технологический институт Балтийская Кировский завод Автово Ленинский проспект Проспект Ветеранов Парнас Озерки Удельная Пионерская Чёрная речка Петроградская Горьковская Невский проспект Сенная площадь Фрунзенская Московские ворота Электросила Парк Победы Московская Звёздная Купчино Беговая Зенит Приморская Василеостровская Гостиный двор Маяковская Площадь Александра Невского Елизаровская Ломоносовская Пролетарская Обухово Спасская Достоевская Лиговский проспект Площадь Александра Невского Новочеркасская Ладожская Проспект Большевиков Улица Дыбенко Комендантский проспект Старая Деревня Крестовский остров Чкаловская Спортивная Адмиралтейская Садовая Звенигородская Обводный канал Волковская Бухарестская Международная Проспект Славы Дунайская Шушары Богатырская Каменка Театральная Горный институт Путиловская Юго-Западная Кудрово Шуваловский проспект Каретная Боровая Заставская БроневаяРайон
Центральный Выборгский Кировский Адмиралтейски Василеостровский Калининский Колпинский Красногвардейский Красносельски Кронштадтский Курортный Московский Невский Петроградский Петродворцовый Приморский Пушкинский ФрунзенскийГород
Санкт-Петербург Бокситогорск Бугры Волосово Волхов Всеволожск Выборг Высоцк Гатчина Ивангород Каменногорск Кингисепп Кириши Кировск Колтуши Коммунар Кудрово Лодейное Поле Луга Любань Мурино Никольское Новая Ладога Отрадное Пикалёво Подпорожье Приморск Приозерск Светогорск Сертолово Сланцы Сосновый Бор Сясьстрой Тельмана Тихвин Тосно ШлиссельбургЦены
Услуги, соответствующие запросу, не найдены.
Адреса диагностических центров "Доступная Медицина"
Преимущества наших диагностических центров
Доступные цены
Приемлемые цены
на все услуги
Качественный сервис
Контроль качества
оказываемых услуг
Лучшие специалисты
Высококвалифицированные врачи
Новейшее оборудование
Современные томографы с высочайшим качеством визуализации
Близость к метро
Мы находимся в непосредственной близости от метро и остановок общественного транспорта
Наше оборудование
КТ-СПЕЦИАЛИСТЫ
Лицензии
Современные томографы с высочайшим качеством визуализации
Статьи наших врачей